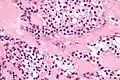

Hyalinizing clear cell carcinoma
Hyalinizing clear cell carcinoma (HCCC) is a rare malignant salivary gland tumour, with a good prognosis, that is usually found on the tongue or palate.[1]
| Hyalinizing clear cell carcinoma | |
|---|---|
 | |
| Micrograph of a hyalinizing clear cell carcinoma showing the characteristic clear cells and surrounding hyalinized stroma. H&E stain. | |
| Specialty | Oncology, ENT surgery |
Diagnosis
HCCCs are diagnosed by examination of tissue, e.g. a biopsy.
Pathology
HCCC consist of cells with abundant clear cytoplasm, arranged in cords, trabeculae or clusters in a hyalinized stroma.[3] Nuclear pleomorphism is usually minimal and mitoses are infrequently seen.[2]
Owing to their glycogen content, which explains the "clear" appearance under the microscope, tumour cells stain with PAS. Immunostains for S100 and smooth muscle actin (SMA) are typically negative, but positive for cytokeratins and epithelial membrane antigen (EMA).
HCCCs typically have a recurrent chromosomal translocation, t(12;22), involving the genes EWSR1 and ATF1.[4] The same translocation is seen in clear cell sarcoma.
The histologic differential diagnosis includes mucoepidermoid carcinoma (clear cell variant), acinic cell carcinoma (clear cell variant), epithelial-myoepithelial carcinoma and metastatic clear cell carcinoma.
 Intermed. mag.
Intermed. mag. Very high mag.
Very high mag.
Prognosis
They generally have a good prognosis.[5]
See also
References
- Kauzman, A.; Tabet, JC.; Stiharu, TI. (Jul 2011). "Hyalinizing clear cell carcinoma: a case report and review of the literature". Oral Surg Oral Med Oral Pathol Oral Radiol Endod. 112 (1): e26–34. doi:10.1016/j.tripleo.2011.02.041. PMID 21669357.
- Milchgrub, S.; Gnepp, DR.; Vuitch, F.; Delgado, R.; Albores-Saavedra, J. (Jan 1994). "Hyalinizing clear cell carcinoma of salivary gland". Am J Surg Pathol. 18 (1): 74–82. doi:10.1097/00000478-199401000-00007. PMID 7506496.
- O'Sullivan-Mejia, ED.; Massey, HD.; Faquin, WC.; Powers, CN. (Sep 2009). "Hyalinizing clear cell carcinoma: report of eight cases and a review of literature". Head Neck Pathol. 3 (3): 179–85. doi:10.1007/s12105-009-0124-3. PMC 2811632. PMID 20596970.
- Antonescu, CR.; Katabi, N.; Zhang, L.; Sung, YS.; Seethala, RR.; Jordan, RC.; Perez-Ordoñez, B.; Have, C.; et al. (Jul 2011). "EWSR1-ATF1 fusion is a novel and consistent finding in hyalinizing clear-cell carcinoma of salivary gland". Genes Chromosomes Cancer. 50 (7): 559–70. doi:10.1002/gcc.20881. PMID 21484932.
- Masilamani, S.; Rao, S.; Chirakkal, P.; Kumar, AR. (2011). "Hyalinizing clear cell carcinoma of the base of tongue: a distinct and rare entity". Indian J Pathol Microbiol. 54 (1): 167–9. doi:10.4103/0377-4929.77393. PMID 21393908.